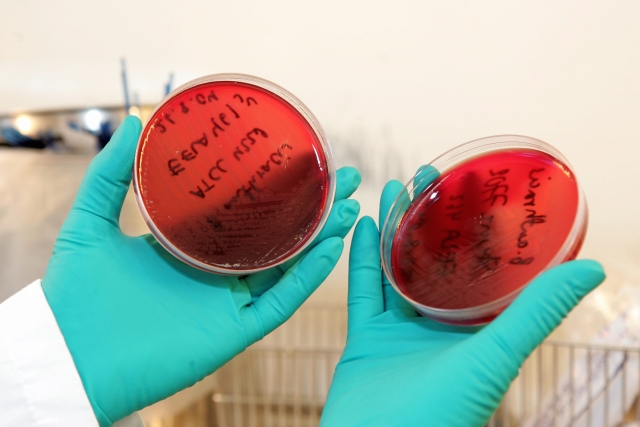

Šestaosmdesát amerických pracovníků vládní laboratoře zkoumající nebezpečné nemoci se možná nakazilo antraxem. Upřesnilo to americké Centrum pro kontrolu chorob (CDC), které původně ve čtvrtek hovořilo o nejméně 75 možných nakažených osobách. Podle předběžných závěrů CDC byla příčinou neopatrná manipulace se vzorky. Případ šetří FBI, která nezjistila ničí nekalý úmysl.
K možné nákaze došlo podle stanice CNN poté, co byly vzorky bakterie obsahující antrax přemístěny z laboratoře s vyšším stupněm zabezpečení do jiného, méně zabezpečeného pracoviště v rámci centra v metropoli státu Georgia Atlantě. Laboranti je však zapomněli "deaktivovat", což způsobilo jejich nakažlivost. "Pracovníci, kteří se domnívali, že vzorky byly deaktivovány, nepoužili adekvátní osobní ochranné vybavení, když pracovali s materiálem," uvedlo CDC v prohlášení.
Pracovníci laboratoře byli možné nákaze vystaveni 13. června, inkubační doba nemoci zvané též sněť slezinná je obvykle pět až sedm dní. Zatím prý nejeví známky choroby, ta se však může projevit právě v těchto dnech. Centrum jim proto nabídlo léčbu antibiotiky a protiantraxovou vakcínu.
Federální policie, která na vyšetřování případu pracuje, podle Reuters nezjistila žádné úmyslné zavinění.
Antrax se však v USA stal v minulosti nebezpečnou biologickou zbraní, když jej například v roce 2001 dostalo poštou několik politiků. Otrávené zásilky vedly v zemi k pěti úmrtím. Kvůli možnému riziku opakování zneužití této bakterie chtějí na šetření případu dohlížet i zákonodárci. "Když jde o výzkum bioteroru, není místo na chybu či nedbalost, a musí být přijata veškerá opatření k zajištění bezpečnosti našich vědců," uvedl šéf sněmovního výboru pro energetiku a obchod Fred Upton.
| Sněť slezinná |
| Může zasáhnout tři oblasti lidského organismu. Příznaky plicního antraxu se podobají nejdříve silné chřipce, pak silnému zápalu plic, nakonec nastává respirační selhávání. Střevní antrax způsobuje vážnou infekci žaludku a střev a projevuje se mimo jiné horečkami a prudkými bolestmi doprovázenými krvavými průjmy a zvracením. U kožního antraxu bývá prvním projevem svědivé místo nebo puchýř tmavé barvy v místě infekce. Posléze se objevují velké, nebolestivé vředy. Všechny tři formy se léčí pomocí antibiotik, přičemž klíčová je včasná diagnóza |